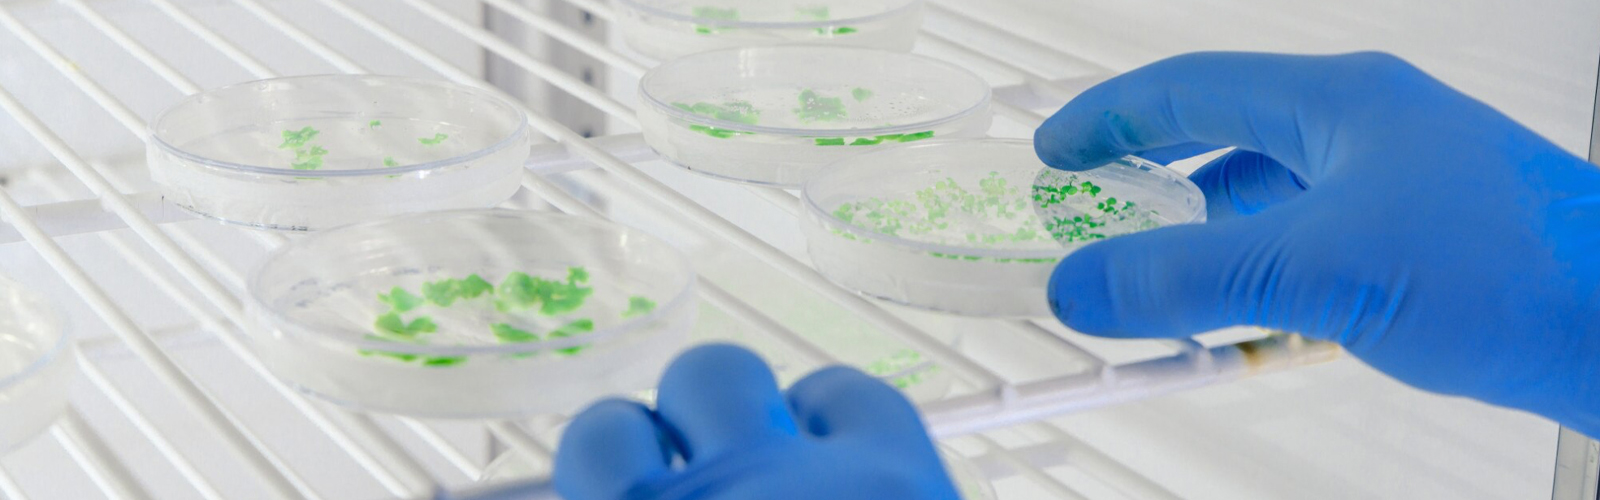

Plant Tissue Culture
Java Biocolloid’s high-quality agar provides a stable, nutrient-rich medium for plant tissue culture, ensuring optimal growth, clarity, and consistent results.
Agar is an essential hydrocolloid in plant tissue culture, providing a stable and nutrient-rich medium for optimal plant growth and development. Derived from red seaweed, agar acts as a natural gelling agent, creating a firm yet porous structure that supports root formation and cellular differentiation. Its high clarity, purity, and consistent gel strength make it ideal for micropropagation, seed germination, and genetic research. At Java Biocolloid, we can supply premium-quality agar designed to meet the precise needs of plant tissue culture applications, ensuring reliable results for researchers, horticulturists, and commercial growers alike.
Products

Agar-based gelling agent designed for controlled nutrient availability and consistent hydration, offering a non-toxic, inert medium with high transparency; ideal for applications requiring clarity and stability.